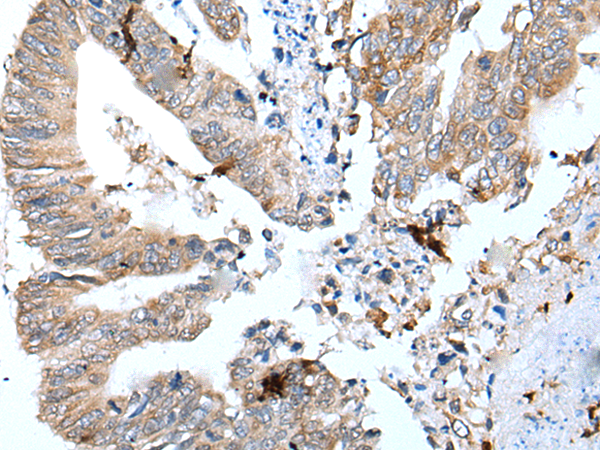

中文名稱: 兔抗GKN1多克隆抗體
技術(shù)規(guī)格
|
Background: |
Gastrokine 1 (GKN1), a stomach-speci c protein also known as 18 kDa antrum mucosa protein (AMP-18) or foveolin, belongs to the gastrokine family of gastric mucus cell-secreted proteins. The human GKN1 gene has been localized in a region of chromosome 2p13 of about 6 kb and contains 6 exons. GKN1 is expressed only in normal human stomach, but is absent from gastric adenocarcinomas, gastro-esophageal adenocarcinoma cell lines, and other normal and tumor gastro-intestinal tissues. GKN1may play an important role in normal gastric function and may be a gastric tumour suppressor. |
|
Applications: |
ELISA, WB, IHC |
|
Name of antibody: |
GKN1 |
|
Immunogen: |
Synthetic peptide of human GKN1 |
|
Full name: |
gastrokine 1 |
|
Synonyms: |
FOV; CA11; AMP18; BRICD1; foveolin |
|
SwissProt: |
Q9NS71 |
|
ELISA Recommended dilution: |
5000-10000 |
|
IHC positive control: |
Human colorectal cancer |
|
IHC Recommend dilution: |
25-100 |
|
WB Predicted band size: |
22 kDa |
|
WB Positive control: |
Human stomach tissue lysate |
|
WB Recommended dilution: |
500-2000 |

購(gòu)物車
幫助
021-54845833/15800441009
